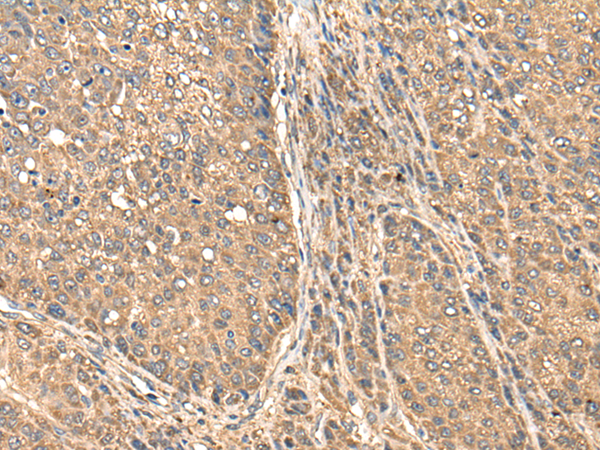

中文名稱:兔抗BAALC多克隆抗體
|
Background: |
This gene was identified by gene expression studies in patients with acute myeloid leukemia (AML). The gene is conserved among mammals and is not found in lower organisms. Tissues that express this gene develop from the neuroectoderm. Multiple alternatively spliced transcript variants that encode different proteins have been described for this gene; however, some of the transcript variants are found only in AML cell lines. |
|
Applications: |
ELISA, IHC |
|
Name of antibody: |
BAALC |
|
Immunogen: |
Full length fusion protein |
|
Full name: |
brain and acute leukemia, cytoplasmic |
|
SwissProt: |
Q8WXS3 |
|
ELISA Recommended dilution: |
5000-10000 |
|
IHC positive control: |
Human liver cancer |
|
IHC Recommend dilution: |
25-100 |
購(gòu)物車
幫助
021-54845833/15800441009
